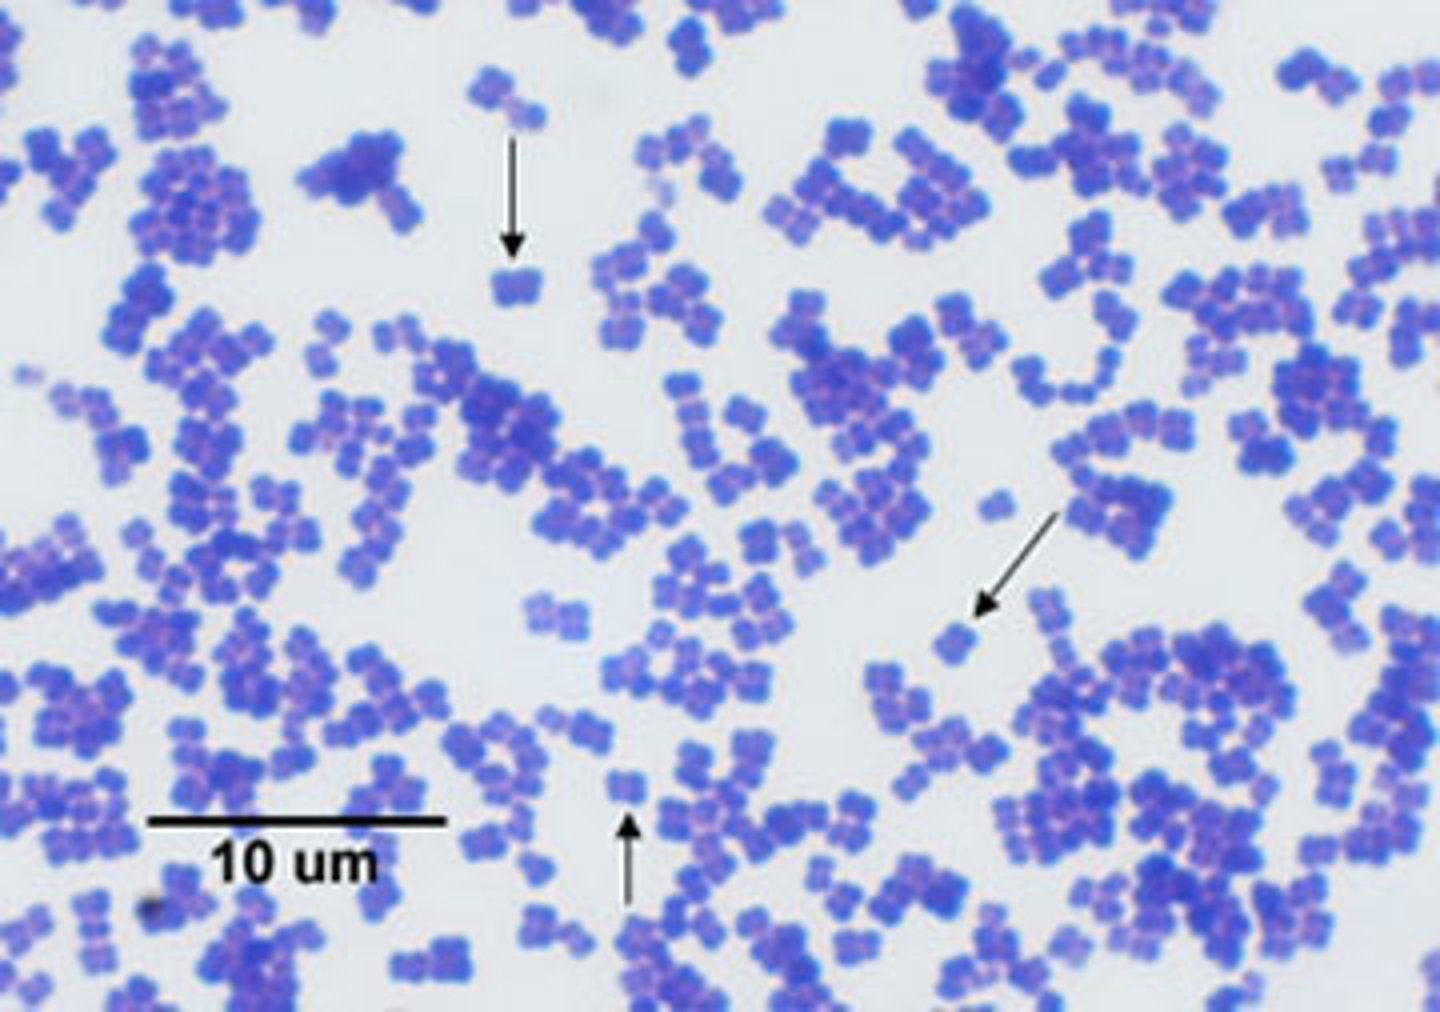
<p>What bacterial arrangement is pictured here?</p>

1/29
Looks like no tags are added yet.
Name | Mastery | Learn | Test | Matching | Spaced |
|---|
No study sessions yet.
Simple stain
What type of stain is this?

Negative stain
What type of stain is this?

Acid fast stain
What type of stain is this?

Gram stain
What type of stain is this?

Endospore stain
What type of stain is this?

Capsule stain
What type of stain is this?

Flagellar stain
What type of stain is this?

Background
What is stained here?

Cell wall
What cellular structure is stained here?

Cell wall
What cellular structure is stained here?

Endospore
What cellular structure is stained here?

Capsule
What cellular structure is seen here?

Flagella
What cellular structure is stained here?

Amphitrichous
What flagellar arrangement is pictured here?

Atrichous
What flagellar arrangement is pictured here?

Peritrichous
What flagellar arrangement is pictured here?

Monotrichous
What flagellar arrangement is pictured here?

Lophotrichous
What flagellar arrangement is pictured here?

Gram positive
What gram reaction is pictured here?

Gram negative
What gram reaction is pictured here?

Cocci
What bacterial morphology is pictured here?

Bacilli
What bacterial morphology is pictured here?

Endospores
Predict what are the clear circles found in this Gram stain.

Spirilla
What bacterial morphology is pictured here?

Staphylococci
What bacterial arrangement is pictured here?

Streptococci
What bacterial arrangement is pictured here?

Streptobacilli
What bacterial arrangement is pictured here?

Tetrad
What bacterial arrangement is pictured here?
Diplococcus
What bacterial arrangement is pictured here?

Single
What bacterial arrangement is pictured here?
